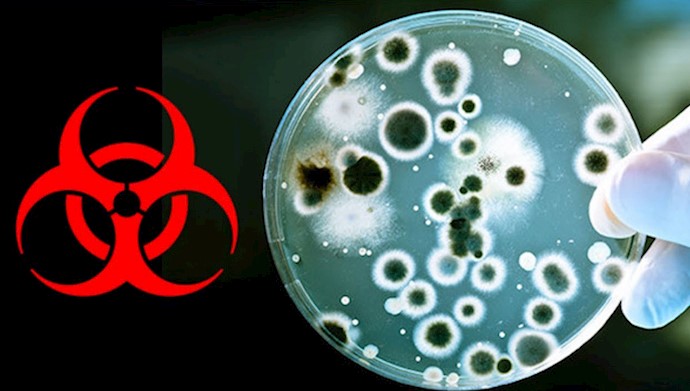

Analysis by PMOI/MEK
Iran, July 9, 2019 – The Atlanta prosecutors office has accused an Iranian regime dealer of violating United States sanctions and plotting to export biological material from the U.S. to Iran against a United Nations resolution.
AP reported that when an Iranian academic by the name of Masoud Soleimani touched down on U.S. soil last fall, returning from Iran, federal authorities armed with a secret indictment arrested him on charges indicating he had violated trade sanctions by trying to have biological material brought to Iran. Nine months later, as tensions escalate between the two countries, Soleimani sits in a detention center just south of Atlanta.
Federal prosecutors say the attempted transport was illegal and secretly obtained an indictment against Soleimani in June 2018. Government officials revoked his visa and arrested him in October when he landed in Chicago.
Soleimani and two of his former students are accused of conspiring and attempting to export biological materials from the U.S. to Iran without authorization. The two counts each carry a maximum penalty of 20 years in prison.
The U.S. attorney’s office in Atlanta declined to comment, but prosecutors have argued in court filings that the comprehensive sanctions in place for years do not allow goods to be exported to Iran except under very limited conditions that don’t apply in this case.
The U.S. and other world powers announced an agreement with Iran in July 2015 that said that country would curb its nuclear activities in exchange for the lifting of international sanctions, though the U.S. did impose new sanctions after Iran tested ballistic missiles.
After U.S. President Donald Trump came into office, tensions escalated and he pulled the U.S. from the nuclear deal in May 2018. Prosecutors in Atlanta obtained an indictment against Soleimani the following month.